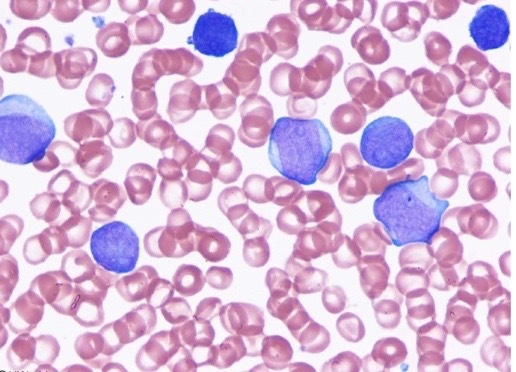

An 8-year-old boy was admitted with a history of fever, anorexia and pallor of 10
days duration. Positive findings on physical examination also included presence
of petechiae and hepato-splenomegaly. NO Testicular abnormality. Diagnosis of acute lymphocytic leukemia was confirmed by bone
marrow evaluation. He was induced into remission and CNS-prophylaxis was
started using intrathecal methotrexate. Once these were completed, maintenance therapy
was initiated using oral methotrexate and 6-mer-capto-purine.
Q1: why do we give CNS-prophylaxis ?
trying to prevent leukaemia infiltration into the CNS
related to the previous case
Q2:What will be the risk if CNS-prophylaxis is not given in acute leukemia?
meningeal leukemia or Leukemic meningitis
related to the previous case
Q3 : What other place does leukemia cells use as “sanctuary” besides the brain
in a male patient?
in testicle , which is a very bad prognostic sign
related to previous case
Q4:What are some of the side effects of intrathecal medications?
leukoencephalopathy and
mineralizing micro-angiopathy.
A 55-year-old man came with chief
complaints of gradually increasing fatigue, abdominal fullness and anorexia of
6 weeks . Physical examination revealed normal vital signs, with hepatosplenomegaly
He was referred to a tertiary care hospital where a chest radiogram &abdominal ultrasound examination did not reveal any additional abnormalities.
The CBC was done and it showed the following features:
WBC: 165 x 109
/L Platelets: 600 x 109
/L; Hemoglobin: 12g/dL
basophils 4%, neutrophil bands 15%, metamyelocytes 13%, myelocytes 10%,
promyelocytes 5%, blasts 2%.
Q1: what is the most likely diagnosis ?
Chronic myeloid leukemia
related to the previous case
Q2 :What is the cytogenetic abnormality that is diagnostic for this condition?
presence of the Ph1 chromosome (Philadelphia chromosome
related to the previous case
Q3: what is your treatment of choice ?
imatinib mesylate :
inhibits the BCR-ABL protein
A 41-year-old previously healthy woman comes to the office due to weakness and easy fatigability. She also has had several episodes of epistaxis and gum bleeding. Physical examination reveals mucosal pallor. Further evaluation demonstrates that the patient has a clonal proliferation of white blood cells containing an abnormal protein. In an experiment, the abnormal cells from the patient are purified and cultured in 2 different plates, one with a vitamin A derivative (plate 1) and the other with control (plate 2). After several days of
incubation, cells in plate 1 are well differentiated compared to those in plate 2, and clonal proliferation is inhibited
what is your diagnosis ?
Acute myeloid leukemia
A 15-year-old previously healthy patient arrives at the emergency department due to progressive shortness of breath. Chest x-ray shows a large mediastinal mass and bilateral pleural effusions. Leukocyte count is elevated, and peripheral blood smear reveals abnormal
white blood cells, as shown below. These cells are positive for terminal deoxynucleotidyl transferase and CD3 and negative for CD19 , what is your diagnosis ?
acute lymphoblastic leukaemia
A 67-year-old woman is evaluated for worsening fatigue and exertional dyspnea. She has no prior medical conditions and takes no medications. The patient does not use tobacco, alcohol,
or illicit drugs and consumes a balanced diet. Vital signs are within normal limits. Physical examination is notable for mucosal pallor. Stool testing for occult blood is negative.
Laboratory studies reveal that hemoglobin is 6.7 g/dl, white blood cell count is 35,000/mm 3 ,
and platelets are 45,000/mm 3 * population is shown below.
Peripheral blood flow cytometry of the white blood cell
what is your diagnosis ?

Chronic lymphocytic leukemia


